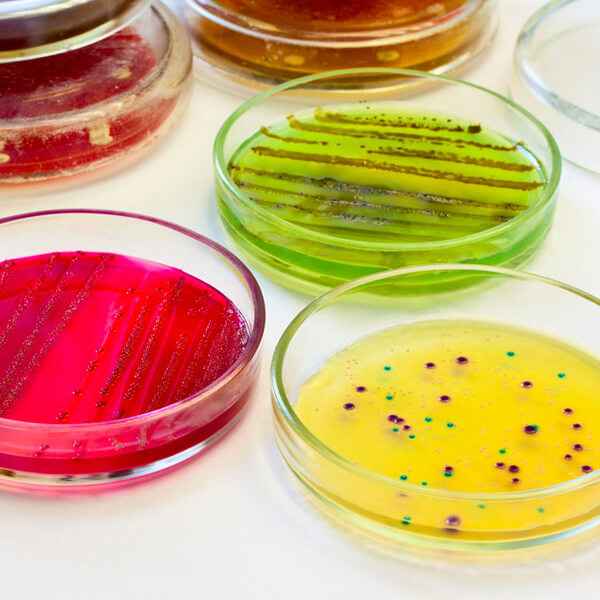
Empleabilidad

Cargando...
Cargando... Cargando...
Cargando...
El Curso de Enfermedades infecciosas causadas por hongos está certificado con 100 Horas, 4 Créditos ECTS por la prestigiosa Universidad San Jorge. Todo el personal que realice un Curso, Máster o Experto Universitario de Formación Alcalá avalado por la Universidad San Jorge (USJ), recibirá, en caso de realizar un Máster o un Experto Universitario un diploma en Créditos ECTS y horas, ya que los estudiantes de estos títulos propios deben ser Diplomados, Graduados o Licenciados, si el programa de formación se trata de un Curso Universitario.
La USJ bajo ningún concepto expedirá el título universitario correspondiente al programa formativo si el alumno/a no ha finalizado con éxito la evaluación correspondiente y no ha transcurrido el tiempo mínimo desde la matrícula. Una vez transcurrido el tiempo mínimo que exige la dicha universidad y finalice la edición, Formación Alcalá procederá a tramitar el expediente académico a la Universidad San Jorge para que esta expida los diplomas, los cuales serán enviados a cada uno de los alumnos por Formación Alcalá, este trámite suele tardar unos cuatro meses para los Cursos Universitarios y de seis a nueve meses cuando se trata de Máster o Expertos Universitarios.

La inscripción en este curso online / a distancia permanecerá abierta durante todo el año.
El discente tendrá un tiempo máximo de 6 meses para su finalización.
La evaluación se realiza online y estará compuesta:
El alumno debe finalizar el curso y hacerlo con aprovechamiento de, al menos, un 50% en cada actividad que deben realizar.
Este programa formativo online / a distancia está dirigido a todo aquel personal de:
Tu formación a distancia se adapta a ti gracias a nuestra plataforma online. Podrás acceder al contenido, descargar materiales y realizar tu formación desde cualquier lugar, sin barreras.
La orientación profesional tiene el objetivo de responder a la creciente demanda de los profesionales por adquirir las competencias y habilidades necesarias para desarrollar las actividades específicas de su ámbito laboral con las mayores garantías de éxito y calidad. Estas competencias permiten que estos profesionales se conviertan en referentes en la excelencia de los cuidados en diversas áreas.
En este sentido, nuestros programas formativos están diseñados y elaborados por profesionales de la salud con años de experiencia, por lo que están enfocados a que los alumnos adquieran esas competencias y habilidades prácticas.
¿Qué beneficios puedes obtener al realizar uno de nuestros programas formativos?